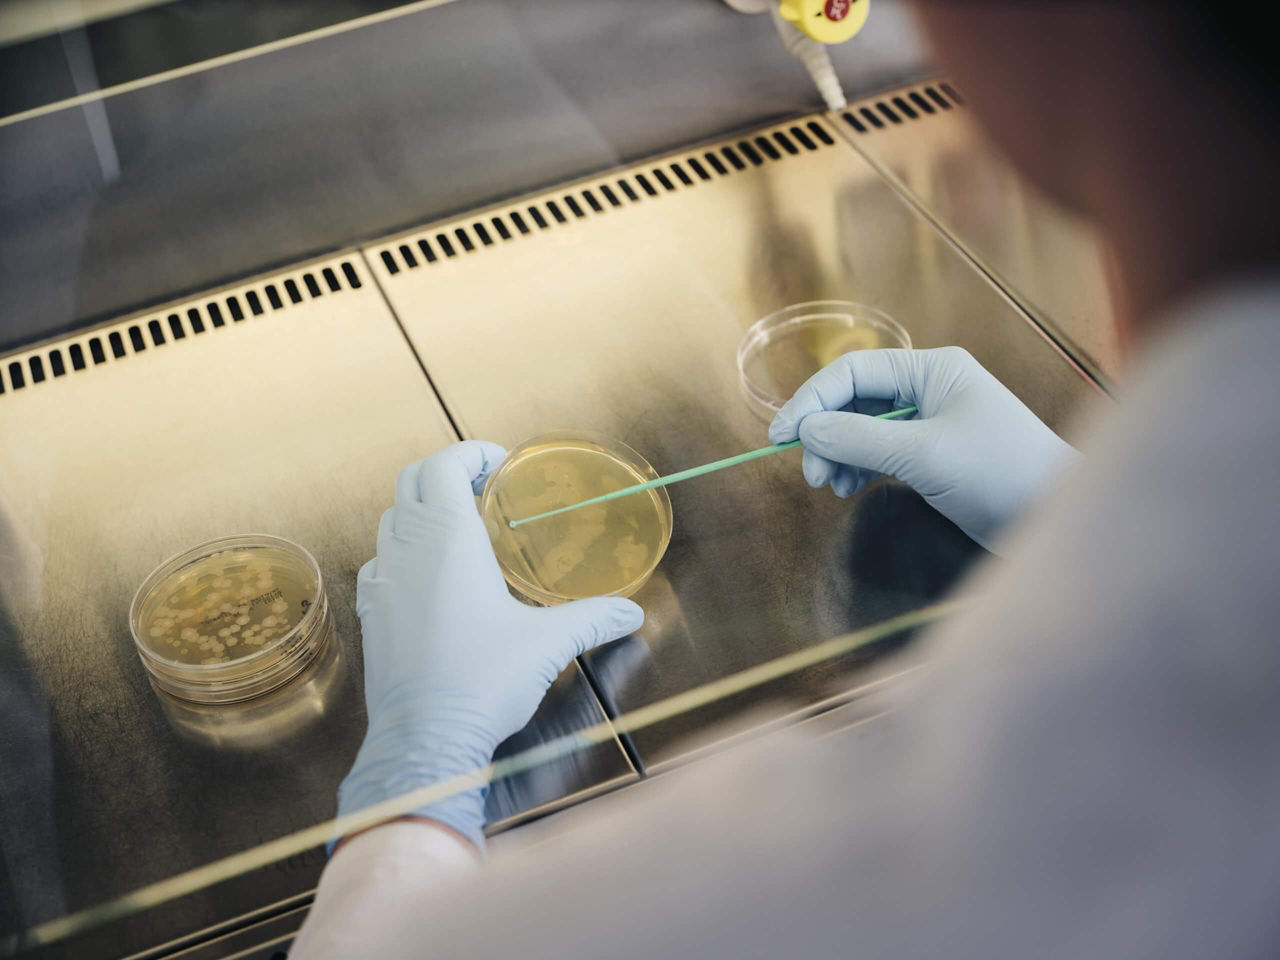
One hand holds a Petri dish, the other hand inoculates the nutrient solution with bacteria.

The human race has solved many of its problems with the help of chemistry. For example, the invention of ammonia-based fertilizer in the early 20th century made it possible to sufficiently feed the world’s rapidly growing population. But there are some challenges for which even the best chemists cannot find technical solutions that can be implemented cost-effectively. In some of these cases, they are assisted by millions of tiny helpers riding to the rescue: bacteria that make it possible to carry out even very complex tasks by means of biotechnical processes. One of the most important such processes is fermentation.
Its effect has been utilized for centuries in areas such as winemaking. But it was not until the 19th century that Louis Pasteur, the French pioneer of microbiology, made the basic principles of fermentation the object of scientific research. Pasteur identified the Some coveted products cannot be produced by simply using chemical processes. In many cases, microorganisms can help. Through fermentation, microorganisms can easily bring about even complicated reactions—if the right strains are used and the process know-how is correct.
The full potential
Powerful by their very nature, bacteria can easily synthesize a wide variety of substances mechanism by which grape juice ferments to form wine. The crucial drivers of this process are microorganisms that have no need of oxygen. Pasteur coined the term “fermentation” for this process, which takes place in the absence of air. In the field of biotechnology, fermentation is defined more extensively today. It now refers to the conversion of organic molecules by means of bacterial, fungal or cell cultures or through the addition of enzymes.
The full potential of fermentation is only being genuinely realized today. One example of that is lysine. This is an amino acid that human beings and animals need as a building block for proteins. Because their bodies cannot produce lysine on their own, they must take it in with their food. For many farm animals, lysine is indispensable for a balanced diet and optimal feed conversion. But there’s a problem: Only natural lysine, which is known as the L-form, can be used by the body, and producing it chemically is a very complex process. In the 1980s, chemists at Degussa, one of Evonik’s predecessor companies, tried in vain for a long time to produce the L-form cost-effectively on an industrial scale. That’s because traditional chemical processes always produce a 50-50 mixture of the L-form and the D-form of lysine. These two forms of a molecule are like the left and right hands of a human being: They are not identical, but instead mirror each other. The breakthrough came with the introduction of a fermentation process, because certain bacteria selectively form the desired biologically active L-form. “When the organism and the process are right, even the most complex molecules can be derived from a carbon source such as sugar,” says Dr. Timo May, an expert in fermentation processes at Evonik. Today one of the company’s most important technology platforms is derived from the process for producing L-lysine that was discovered back then.

»Even the most complex molecules can be derived from sugar«
DR. TIMO MAY, HEAD OF THE FERMENTATION PROCESSES GROUP AT EVONIK’S BIOTECHNOLOGY RESEARCH PLATFORM
From animal feed to medicine
L-lysine is only one of many products that can be manufactured cost-effectively thanks to fermentation. The areas of application of microbial processes range from animal feed to cosmetics and medicine. As a rule, fermentation processes are also more sustainable than traditional methods of production. They use renewable raw materials, are efficient, and make it possible to produce bioproducts. One example of the latter is the algae oil that Evonik produces by means of a fermentation process in a joint venture with Veramaris. It contains the omega-3 fatty acids DHA and EPA and also promotes environmentally friendly fish farming. Another example is rhamnolipids, the first biosurfactants in the world to be produced on an industrial scale. Thanks to fermentation processes, they are especially degradable.
Customized and ultrapure collagens have also recently been produced by bacteria. These structural proteins are needed in areas that include cosmetics and medical technology in order to smooth away wrinkles, heal cartilage defects, and much more. Conventional production processes use starting materials of animal origin. Production processes that use specialized bacteria eliminate the risk of variations in quality, allergic reactions, and the transmission of illnesses. As a result, they increase safety. A brand-new application is the biotechnological production of nanostructured cellulose, which is used as a dressing in modern wound treatment.

The biologist Timo May and his colleagues are fascinated by the way that microorganisms produce highly complex molecules. “They can conduct several desired reactions simultaneously—reactions that would require consecutive steps in a chemical synthesis and would therefore require very complex equipment,” he says.
This capability also makes it possible to conduct processes such as artificial photosynthesis, in which carbon dioxide and water form specialty chemicals when exposed to solar energy. Evonik has joined forces with Siemens to develop this technology. The researchers at Evonik are working to develop a type of fermentation in which bacteria produce specialty chemicals. A pilot plant is now operating at the Evonik location in Marl.
ELEMENTS-Newsletter
Receive exciting insights into Evonik's research and its social relevance - conveniently by e-mail.

SEARCHING FOR THE BEST STRAIN
In order to conduct biotechnological production at the top level, expertise in three areas is required: the development of bacterial strains, fermentation, and the refinement of the products. “Biotechnology is much more interactive than chemistry,” says Dr. Wilfried Blümke, the head of the innovation group for the refinement of biotechnologically produced substances. That’s because in biotechnology three components—the organism, the reactor, and the refinement process—all interact strongly with one another. “Only by working as a team can we decide in every individual case on what level we solve a certain problem,” he says. The first task of the scientists is to find a microorganism that can produce the desired product naturally. For example, the bacterial strains Escherichia coli and Corynebacterium glutamicum have proved to be dependable producers of amino acids.
The microorganism is optimized during the process of strain development. The goal is to get the microorganism to convert as much as possible of its carbon source, usually sugar, into the desired product. If the organism that has been found is not suited for industrial production, for example because it is pathogenic to human beings, molecular biologists transfer the relevant genes into a harmless microorganism that has proved its dependability.
FROM A BROTH TO A PRODUCT
During the first phase inside the fermenter, the microorganisms are still allowed to multiply and form biomass. Then, at a certain point in time, they are expected to direct their metabolic processes toward creating the desired product. The biotechnologists control this change of direction by adding or removing certain substances, for example. After a period that may last anywhere between a few hours and several days, the microorganisms are inactivated and the fermentation broth is drained off. Finally the desired product can be extracted from this broth.
“The refinement process varies, depending on the type of product,” says Blümke. That’s why the bioengineers confer with the marketing experts at an early stage in order to precisely customize the process. In many cases, several consecutive separation processes, such as filtration, centrifugation, and extraction, are needed. For example, in the production of a probiotic—in other words, living bacteria in spore form—a gentle drying process is very important. As a component of a dietary supplement or feed additive, the bacteria of course need to become active once again inside the guts of people or animals so that they can deliver their valuable metabolic products.

“We are looking for the most robust and most cost-effective of all the possible solutions,” says Blümke. In this case, “robust” means that the refinement process delivers a product that precisely fulfills the quality requirements even if the results of the fermentation process vary. Between approximately 20 and 30 tried and tested refinement processes are available to the biochemical engineers at Evonik. All of the steps are modeled and simulated in the laboratory, then tested and improved in a pilot plant, and finally—if everything works well and the product is successful on the market— implemented on an industrial scale.
But at that point, the experts are still not satisfied. Even in a large-scale technical installation, biotechnological processes are constantly being optimized. For example, a higher-performing microorganism makes it possible to adapt the production and refinement process. Conversely, the bacterial strains are developed further in order to make even more cost-effective processes possible. The ultimate goal is to enable the ancient cultural technique of fermentation to help solve mankind’s present-day problems sustainably with the help of cutting-edge scientific efficiency.

